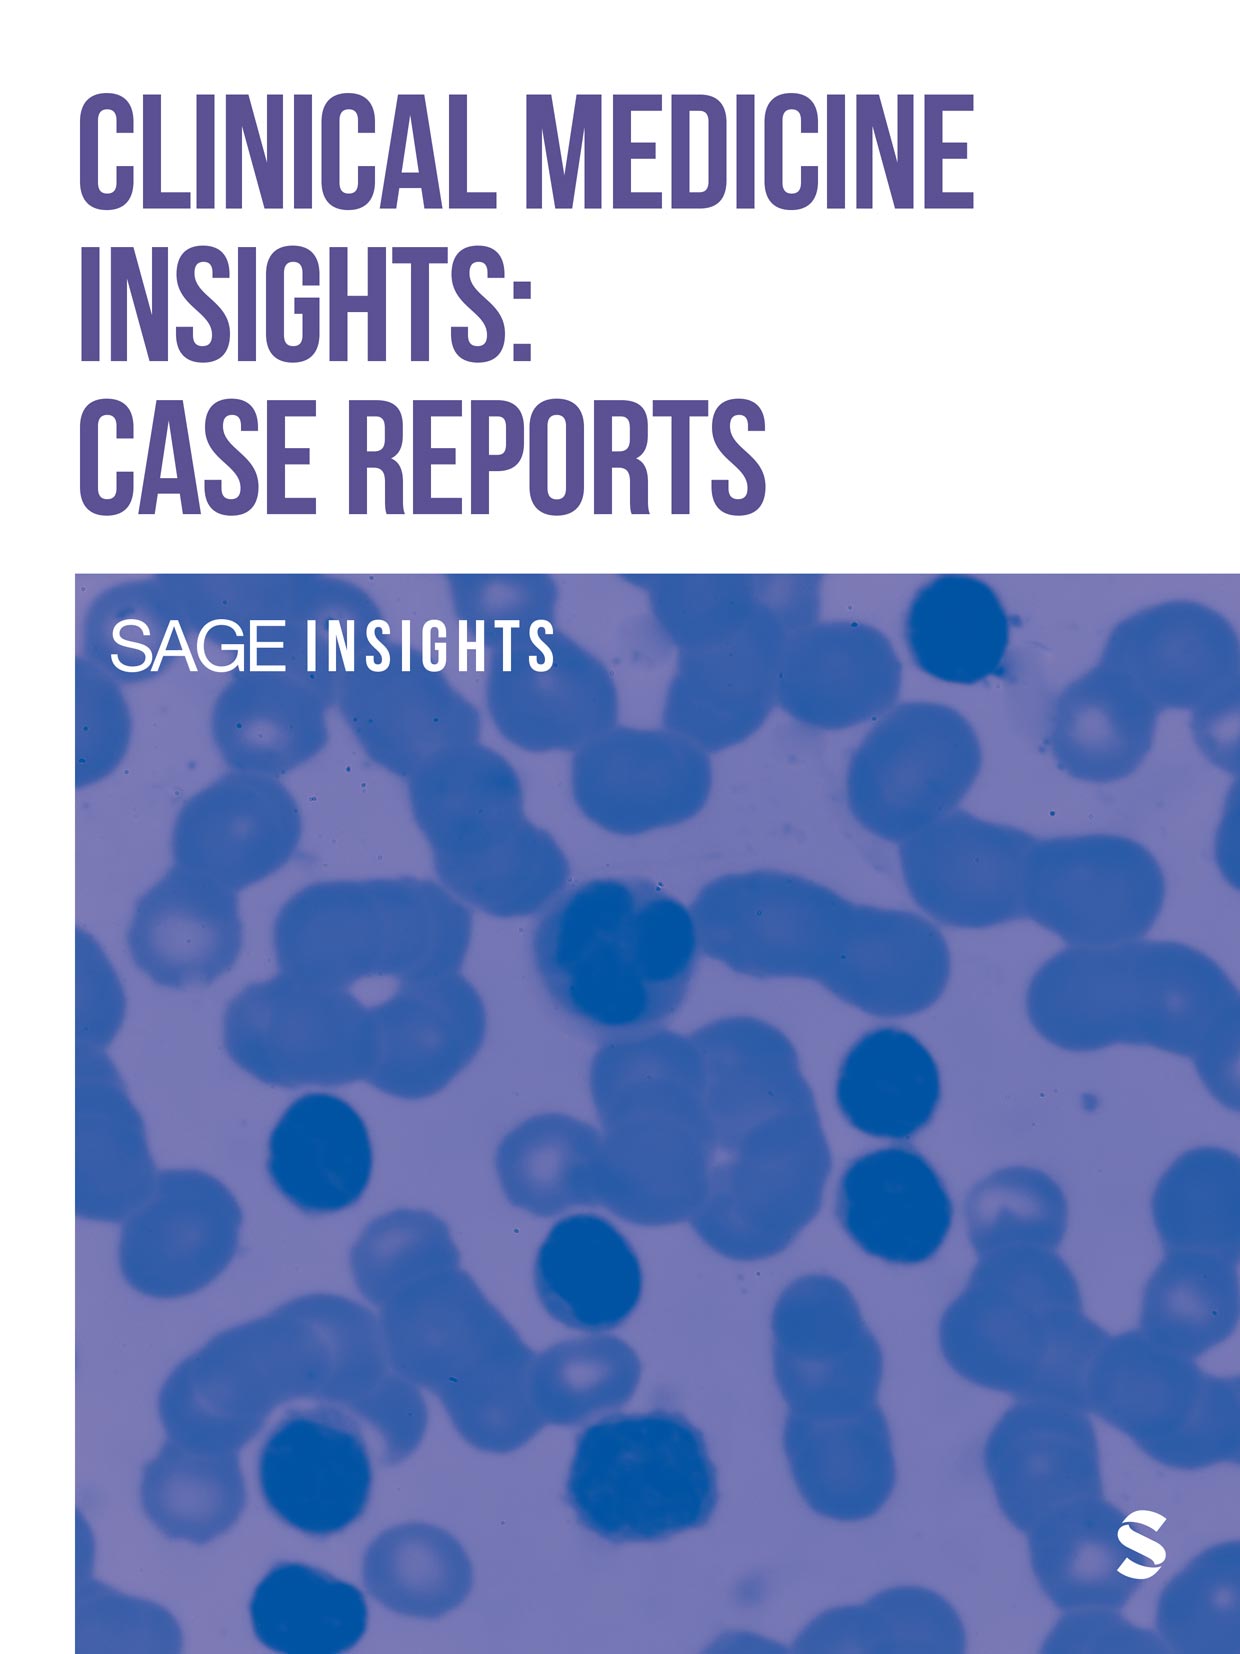

Skip to main content



Sage Clinical Medicine & Surgery features a portfolio of quality journals across the spectrum of the field. We partner with some of the most respected and prestigious societies from around the world to maximize the global dissemination of high impact research.
Download special issues, collections, and selection of recently published articles. Browse our journal portfolio. Explore our videos, podcasts and more.
Clinical medicine & surgery books, digital products, collections & podcasts

Browse our US & UK Books list

Sage Digital Library Products list

Why Publish with JPSN?
Discover the top reasons to publish with Journal of Pediatric Surgical Nursing here.
Editor's Choice Collection
Explore top articles selected by the editor of Clinical Thyroidology®.
Seminars in Cardiothoracic and Vascular Anesthesia call for papers
Submit to SCVA today! Follow the link below to view the submission guidelines, learn more about the journal's aims and scope, and see the Special Collections currently accepting submissions.
Reasons to publish with IJAO
Discover the top reasons to publish with IJAO, including:- Established credibility and prestige
- Diverse content
- Global reach and visibility
- Practical clinical relevance

JCMS Author Interview podcasts
Enhance your learning with author interviews from the Journal of Cutaneous Medicine and Surgery (JCMS), hosted by the Canadian Dermatology Association.
Sage Clinical Medicine podcasts
Stay up to date with the latest in clinical medicine with Sage for Clinical Medicine & Research, featuring podcasts covering groundbreaking research, emerging trends, and expert insights shaping the future of patient care and medical practice
Latest tweets
Additional clinical medicine & surgery resources
Upcoming webinar: Publishing as a Clinician
Register for How to Do Research and Get Published - Publishing as a Clinician on August 12, 2026SAj Blog
The Association for Multidisciplinary Education and Research in Substance use and AddictionAMERSARead the InnovAiT Blog
Royal College of General Practitioners (RCGP)Attend an event
The Royal Society of Medicine (RSM)

Explore all Discipline Hubs, including:
- Journal portfolios in each of our subject areas.
- Links to Books and Digital Library content from across Sage.
Also from Sage
- CQ Library Elevating debateopens in new tab
- Sage Data Uncovering insightopens in new tab
- Sage Business Cases Shaping futuresopens in new tab
- Sage Campus Unleashing potentialopens in new tab
- Sage Knowledge Multimedia learning resourcesopens in new tab
- Sage Research Methods Supercharging researchopens in new tab
- Sage Video Streaming knowledgeopens in new tab
- Technology from Sage Library digital servicesopens in new tab